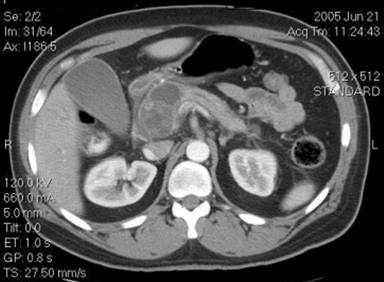

CASE REPORT
JOP. J Pancreas (Online) 2011 May 6; 12(3):250-254.
Azathioprine Induced Pancreatitis in a Patient with Co-Existing Autoimmune Pancreatitis and Hepatitis
Preethi GK Venkatesh, Udayakumar Navaneethan
Digestive Disease Institute, Cleveland Clinic Foundation. Cleveland, OH, USA
ABSTRACT
Context Azathioprine induced pancreatitis usually runs a benign self limited course with rapid disappearance of signs and symptoms upon with drawl of the drug. Azathioprine is used in treating relapses in patients with autoimmune pancreatitis and maintenance of remission in autoimmune hepatitis. Acute pancreatitis complicated by symptomatic pseudocysts requiring drainage is not usually associated with drug induced pancreatitis. The risk of azathioprine use in patients with underlying disease of pancreas including autoimmune pancreatitis is unclear. Case report We report here a case of an African American patient with co-existing autoimmune pancreatitis and autoimmune hepatitis who developed azathioprine induced acute pancreatitis complicated by a large symptomatic pseudocyst compressing the duodenum requiring a cystoduodenostomy. Conclusions Future studies to investigate the risk of azathioprine induced pancreatitis in the presence of underlying disease of the pancreas including autoimmune pancreatitis are required to further understand the safety of azathioprine in this sub group of patients.
INTRODUCTION
Azathioprine is implicated as a definite cause of drug induced pancreatitis [1]. Azathioprine is used in a number of diseases including inflammatory bowel disease (IBD), post transplantation, vasculitis, autoimmune hepatitis; however acute pancreatitis is rarely reported except in IBD [2]. Patients who develop azathioprine associated pancreatitis usually have underlying other factors co-existing/responsible for acute pancreatitis [3, 4].
Azathioprine induced pancreatitis is generally mild and rapidly responds to the withdrawal of the drug except in patients following transplantation where a fatal outcome is reported [5, 6]. The incidence of azathioprine induced pancreatitis is more frequent in patients with underlying IBD than other conditions where azathioprine is used. The risk of acute pancreatitis in azathioprine exposed patients is reported to be around 1.4-1.6% [7, 8]. Population based studies report that patients treated with azathioprine are at eight-fold increased risk to develop acute pancreatitis [9].
Autoimmune pancreatitis is a recently described systemic fibro-inflammatory disease affecting the pancreas along with a variety of other organs including the bile duct, salivary glands, and the retroperitoneum [10, 11, 12]. It is characterized histologically by an IgG4-positive lymphoplasmacytic infiltrate [12]. It classically presents with jaundice associated with a pancreatic mass, pancreatic and/or biliary duct strictures and elevation of serum gamma globulin (IgG4), and it responds favorably to steroids [13].
Autoimmune pancreatitis is exceedingly rare in African Americans and has been reported thus far in isolated case reports [14, 15]. Co-existing autoimmune pancreatitis and autoimmune hepatitis or primary sclerosing cholangitis has been reported in literature, given the underlying autoimmune predisposition of this group of patients [16]. Azathioprine has an established role in maintaining remission in autoimmune hepatitis [17] because relapse is much more common in autoimmune hepatitis. However, there is insufficient evidence to support prolonged immunosuppression in patients with autoimmune pancreatitis [18]. Although a recent small study of 28 patients reported that azathioprine was effective in the management of post-treatment relapse; the optimal treatment of relapse is still unclear [19]. The safety of azathioprine in this subgroup of patients is also unclear.
We report here a case of an African American patient with co-existing autoimmune pancreatitis and autoimmune hepatitis who was started on azathioprine for maintenance immunosuppression for autoimmune hepatitis and autoimmune pancreatitis, developed acute azathioprine induced pancreatitis complicated by a large symptomatic pseudocyst compressing the duodenum requiring a cystoduodenostomy.
CASE REPORT
The patient was a 51-year-old African American male who was in his usual state of health. All his symptoms started in October 2002 when he had presented with diffuse non-specific abdominal pain. At that time, he underwent extensive laboratory and imaging workup which was unrevealing. His abdominal pain persisted and no clear etiology was evident. In September 2003, while donating blood, he was found to have elevated liver enzymes. With his abdominal pain and elevated liver enzymes, he was referred to our center for further workup.
Biochemical evaluation revealed abnormal liver function tests (aspartate aminotransferase (AST) 169 IU/L, reference range: 15-40 IU/L; alanine aminotransferase (ALT) 226 IU/L, reference range: 15-40 IU/L; alkaline phosphatase (ALP) 689 IU/L, reference range: 20-140 IU/L; total bilirubin 1.6 mg/dL, reference range: 0.6-1.2 mg/dL). Iron panel, rheumatoid factor, anti-nuclear antibody, anti-mitochondrial antibody and liver panel for hepatitis viruses were negative. Anti-smooth muscle antibodies were positive (1:20). CA 19-9 was elevated at 43 U/mL (reference range: 0-37 U/mL). He was also found to have elevated IgG of 1,985 mg/dL (reference range: 717-1,411 mg/dL) and IgG4 of 253 mg/dL (reference range: 8-140 mg/dL).
Computerized tomography (CT) of the abdomen revealed mild intrahepatic and extrahepatic ductal dilation, prominent pancreatic head, and multiple small hepatic lesions. An endoscopic retrograde cholangiopancreatography (ERCP) was done which revealed a diffuse stricture in the intrahepatic duct, and a small pancreatic duct without strictures with a narrow bifurcation at the level of both the common hepatic ducts. Brushings were negative for malignancy. Endoscopic ultrasound (EUS) showed a hypoechoic enlarged pancreatic head and fine needle aspiration (FNA) was negative for malignancy. With the presence of the pancreatic head mass, an elevated IgG, particularly IgG4, the diagnosis of autoimmune pancreatitis was provisionally made.
Elevated liver function tests and positive smooth muscle antibodies were suspicious for possible co-existing autoimmune hepatitis vs. IgG4 associated cholangitis. Also his ERCP had revealed diffuse intrahepatic ductal stricture. Intraductal biopsy specimens did not show any evidence of IgG4 associated cholangitis, while his liver biopsy did show chronic hepatitis with mild activity grade II, periportal fibrosis with focal bridging fibrosis stage II consistent with the diagnosis of autoimmune hepatitis. He was then started on oral prednisone 50 mg/day with an 8-week tapering course.
Most of the symptoms of the patient, particularly the right upper quadrant abdominal pain, subsided after a few months. His pancreatic head mass also disappeared. His liver enzymes were trending down by May 2004 (AST: 72 IU/L; ALT: 54 IU/L; ALP: 65 IU/L; total bilirubin: 0.8 mg/dL). The patient was continued on maintenance steroids. During a routine clinical follow-up visit in the fall of 2005 for abdominal pain, imaging in the form of abdominal CT was done which showed a lesion in the head of the pancreas measuring 2.1x2.1 cm, a slight increase in the size of an uncinate process lesion measuring 3.0x2.7 cm which was highly suggestive of an inflammatory process. He had a prior CT imaging six months before which showed few cysts in the pancreas; all were small and asymptomatic. Because of the slight increase in the size of the uncinate process cyst, EUS was performed with FNA, which revealed no malignant cells. Azathioprine at a dose of 2 mg/kg was discussed and started with steroids for autoimmune pancreatitis induced pseudocyst and also for maintaining remission in autoimmune hepatitis.
Two weeks after the initiation of azathioprine, he was admitted with severe abdominal pain, nausea and vomiting and elevated amylase and lipase. The pancreatic pseudocyst of the head of the pancreas was increased in size (4.0x3.9 cm), the remainder of the hypodense lesions of the pancreas were also slightly larger in size. A diagnosis of azathioprine-induced pancreatitis was made, as exploration for other causes of worsening was negative. He had a EUS evaluation to rule out other causes including intraductal papillary mucinous neoplasm. He had no history of alcohol abuse or cigarette smoking. There was no evidence of choledocholithiasis and evaluation of the medication list for any cause of pancreatitis other than azathioprine was negative. Azathioprine was stopped and mycophenolate mofetil was started for autoimmune hepatitis and autoimmune pancreatitis. Repeat CT after 4 weeks for persistent abdominal pain, nausea and vomiting showed extrinsic compression of the duodenum by the pseudocyst (Figure 1). ERCP with cyst duodenostomy was performed at that time with subsequent improvement of symptoms and biochemical improvement.
|
Figure 1. CT abdomen showing pseudocyst in the head of the pancreas compressing the common bile duct and duodenum. |
A follow-up CT six months later showed a significant decrease in the size of the pseudocyst (Figure 2). He was pain free and his liver function test at this time has returned to normal. The patient was instructed to continue taking ursodeoxycolic acid, prednisone and mycophenolate mofetil.

|
Figure 2. Complete resolution of the pseudocyst post procedure. |
DISCUSSION
Azathioprine, implicated as a definite cause of drug induced pancreatitis is particularly seen in patients with underlying IBD and following transplantation [1, 2]. Azathioprine induced pancreatitis is generally mild and is believed to be idiosyncratic and dose-independent [20]. It usually has a benign course starts after a latent period of about 3-6 weeks after drug exposure and all signs and symptoms rapidly respond over a period of 1-11 days upon with drawl of the drug [21]. The development of azathioprine-induced pancreatitis is usually considered a contraindication to future use [22]. The risk of acute pancreatitis in azathioprine exposed patients is reported to be around 1.4-1.6% [7, 8] and population based studies report that patients treated with azathioprine are at eight-fold increased risk to develop acute pancreatitis [9]. Studies in animal models suggest that azathioprine causes biochemical and histological evidence of acute pancreatitis [23] and aggravates acinar cell necrosis [24]. Some authors suspect that azathioprine is a co-factor in causing pancreatitis as most patients have additional possible factors for the disease [3, 4]. Given the mild presentation in most patients with azathioprine pancreatitis in the literature, it was really surprising that our patient had a complicated course requiring endoscopic intervention.
Autoimmune pancreatitis is probably one aspect of a multisystem disease characterized by involvement of affected tissues by an IgG4-positive plasma cell infiltrate [10, 11, 12]. It has not been well described in African Americans and has been reported thus far in isolated case reports [14, 15] (personal communication, Dr. Suresh Chari). Our patient was an African American, which is exceedingly rare. The disease process in autoimmune pancreatitis is reported to either spontaneously improve [25, 26, 27] or respond dramatically to steroids [13, 18, 28]. In fact, a response to steroids is a component of the diagnostic algorithm for autoimmune pancreatitis [13, 26]. Nevertheless, the dose and duration of steroid therapy, and long term outcome following treatment is not exactly clear. Several studies report a relapse rate of 19-55% following treatment with steroids [13, 18, 29, 30]. However, the treatment of relapse is unclear. There is insufficient evidence to subject these patients to prolonged immunosuppression [18]. Although a recent small study of 28 patients reported that azathioprine was effective in the management of post-treatment relapse; the controversy still persists [19]. Our patient also had pseudocysts while on treatment with steroids. Autoimmune pancreatitis in general is not usually associated with pseudocysts [31, 32]. Data show that pseudocyst development in autoimmune pancreatitis may occur after prolonged disease activity. Pseudocysts in autoimmune pancreatitis are indicative of active inflammation and may respond well to steroids, unlike pseudocysts not associated with autoimmune pancreatitis [31]. Our patient had pseudocysts because of autoimmune pancreatitis, which continued to persist even with steroid use. The switch to azathioprine in a patient with a small pseudocyst which could have been an indicator of disease activity or pancreatic inflammation may have contributed to more severe pancreatitis.
Autoimmune pancreatitis and autoimmune hepatitis or primary sclerosing cholangitis co-existence has been reported in literature. However whether it is an incidental association or has a clear relevance is not known [16]. Azathioprine has an established role in maintaining remission in autoimmune hepatitis [17]. Relapse is much more common in autoimmune hepatitis and azathioprine is clearly beneficial in these patients. Mycophenolate mofetil can also be used as second-line agent for treating autoimmune hepatitis [33, 34]. We used azathioprine in maintaining remission in patients with autoimmune hepatitis and autoimmune pancreatitis. Two weeks later he developed azathioprine-induced pancreatitis complicated by a pseudocyst which required stopping azathioprine, starting him on mycophenolate mofetil and draining the cyst endoscopically.
The safety of azathioprine in patients with autoimmune pancreatitis is unclear. In a recent small study of 28 patients with autoimmune pancreatitis, 7 patients were maintained on remission with azathioprine monotherapy. No adverse events were reported in the study [23]. Although the preliminary results show that azathioprine was safe and effective in the management of post-treatment relapse; the safety of azathioprine is still unclear as the study population was small [23]. The safety of azathioprine in patients who have other underlying diseases of the pancreas is also not studied yet. In patients with autoimmune hepatitis, azathioprine-induced pancreatitis is reported very rarely [17, 35, 36].
The co-existence of IgG4-associated autoimmune hepatitis and autoimmune pancreatitis has been reported. In a series from Japan, more than 3% of patients with autoimmune hepatitis had IgG4-positive plasma cell deposition in the liver [37]. However, we did not see any IgG4-plasma cell deposition in the liver of our patient. Thus the co-existence of autoimmune hepatitis and autoimmune pancreatitis may be an incidental association.
The development of pancreatitis requiring endoscopic intervention in our patient may have been contributed by the presence of underlying autoimmune pancreatitis with a small pseudocyst to begin with. We hypothesize that azathioprine in the presence of a pre-existing cofactor is more prone to cause pancreatitis and patients with autoimmune pancreatitis have this predisposition with altered pancreatic parenchyma. Thus the second hit in the form of azathioprine could have triggered a severe pancreatitis. The temporal relationship between the drug and the development of symptoms with improvement upon withdrawal of the drug supports azathioprine as the cause for pancreatitis. Further studies are needed to study further our hypothesis.
CONCLUSIONS
Our case report illustrates three important issues. Firstly, the occurrence of autoimmune pancreatitis in the African American population. Secondly, the ability of azathioprine induced pancreatitis to cause symptomatic pseudocyst compressing the duodenum and requiring cystoduodenostomy. Thirdly, our hypothesis that azathioprine induced complications may be more common in patients with underlying disorder of the pancreas like autoimmune pancreatitis, which questions the use of azathioprine in the long term maintenance management of patients with autoimmune pancreatitis particularly since the chances of relapse are relatively low and their treatment is not proven.
Received February 6th, 2011 - Accepted March 16th, 2011
Key words Autoimmune Diseases; Azathioprine; Endoscopy; Pancreatic Pseudocyst; Pancreatitis
Financial support No financial support was provided for this article
Conflict of interest No conflicts of interest to declare
Correspondence
Udayakumar
Navaneethan
Digestive Disease Institute
Cleveland Clinic Foundation
Cleveland, Ohio
USA 44118
Phone: +1-216.502.0981
Fax: +1-216.444.6305
E-mail: navaneu@ccf.org
References
1. Herrlinger KR, Stange EF. The pancreas and inflammatory bowel diseases. Int J Pancreatol 2000; 27:171-9. [PMID 10952399]
2. Kahan BD. Efficacy of sirolimus compared with azathioprine for reduction of acute renal allograft rejection: a randomized multicentre study. The Rapamune US Study Group. Lancet 2000; 356:194-202. [PMID 10963197]
3. Frick TW, Fryd DS, Sutherland DE, Goodale RL, Simmons RL, Najarian JS. Hypercalcemia associated with pancreatitis and hyperamylasemia in renal transplant recipients. Data from the Minnesota randomized trial of cyclosporine versus antilymphoblast azathioprine. Am J Surg 1987; 154:487-9. [PMID 2445214]
4. Frick TW, Fryd DS, Goodale RL, Simmons RL, Sutherland DE, Najarian JS. Lack of association between azathioprine and acute pancreatitis in renal transplantation patients. Lancet 1991; 337:251-2. [PMID 1670892]
5. Haber CJ, Meltzer SJ, Present DH, Korelitz BI. Nature and course of pancreatitis caused by 6-mercaptopurine in the treatment if inflammatory bowel disease. Gastroenterology 1986; 91:982-6. [PMID 2427386]
6. Mallory A, Kern F Jr. Drug induced pancreatitis: A critical review. Gastroenterology 1980; 78:813-20. [PMID 6986321]
7. Bermejo F, Lopez-Sanroman A, Taxonera C, Gisbert JP, Pérez-Calle JL, Vera I, et al. Acute pancreatitis in inflammatory bowel disease, with special reference to azathioprine induced pancreatitis. Aliment Pharmacol Ther 2008; 28:623-8. [PMID 18513380]
8. Sandborn W, Sutherland L, Pearson D, May G, Modigliani R, Prantera C. Azathioprine or 6-mercaptopurine for inducing remission of Crohn's disease. Cochrane Database Syst Rev 2000:CD000545. [PMID 10796557]
9. Floyd A, Pedersen L, Nielsen GL, Thorlacius-Ussing O, Sorensen HT. Risk of acute pancreatitis in users of azathioprine: a population-based case-control study. Am J Gastroenterol 2003; 98:1305-8. [PMID 12818274]
10. Kamisawa T, Funata N, Hayashi Y, Eishi Y, Koike M, Tsuruta K, et al. A new clinicopathological entity of IgG4-related autoimmune disease. J Gastroenterol 2003; 38:982-4. [PMID 14614606]
11. Park DH, Kim MH Dr, Chari ST. Recent advances in autoimmune pancreatitis. Gut 2009; 58:1680-9. [PMID 19240063]
12. Deheragoda MG, Church NI, Rodriguez-Justo M, Munson P, Sandanayake N, Seward EW, et al. The use of immunoglobulin g4 immunostaining in diagnosing pancreatic and extrapancreatic involvement in autoimmune pancreatitis. Clin Gastroenterol Hepatol 2007; 5:1229-34. [PMID 17702660]
13. Chari ST, Smyrk TC, Levy MJ, Topazian MD, Takahashi N, Zhang L, et al. Diagnosis of autoimmune pancreatitis: the Mayo Clinic experience. Clin Gastroenterol Hepatol 2006; 4:1010-6. [PMID 16843735]
14. Hochwald SN, Hemming AW, Draganov P, Vogel SB, Dixon LR, Grobmyer SR. Elevation of serum IgG4 in Western patients with autoimmune sclerosing pancreatocholangitis: a word of caution. Ann Surg Oncol 2008; 15:1147-54. [PMID 18219538]
15. Chen RY, Adams DB. IgG4 levels in non-Japanese patients with autoimmune sclerosing pancreatitis. N Engl J Med 2002; 346:1919. [PMID 12063386]
16. Hamano H, Kawa S, Horiuchi A, Unno H, Furuya N, Akamatsu T, et al. High serum IgG4 concentrations in patients with sclerosing pancreatitis. N Engl J Med 2001; 344:732-8. [PMID 11236777]
17. Johnson PJ, McFarlane IG, Williams R. Azathioprine for long-term maintenance of remission in autoimmune hepatitis. N Engl J Med 1995; 333:958-63. [PMID 7666914]
18. Church NI, Pereira SP, Deheragoda MG, Sandanayake N, Amin Z, Lees WR, et al. Autoimmune pancreatitis: clinical and radiological features and objective response to steroid therapy in a UK series. Am J Gastroenterol 2007; 102:2417-25. [PMID 17894845]
19. Sandanayake NS, Church NI, Chapman MH, Johnson GJ, Dhar DK, Amin Z, et al. Presentation and management of post-treatment relapse in autoimmune pancreatitis/immunoglobulin G4-associated cholangitis. Clin Gastroenterol Hepatol 2009; 7:1089-96. [PMID 19345283]
20. Haber CJ, Meltzer SJ, Present DH, Korelitz BI. Nature and course of pancreatitis caused by 6-mercaptopurine in the treatment if inflammatory bowel disease. Gastroenterology 1986; 91:982-6. [PMID 2427386]
21. Mallory A, Kern F Jr. Drug induced pancreatitis: A critical review. Gastroenterology 1980; 78:813-20. [PMID 6986321]
22. Sturdevant RA, Singleton JW, Deren JL, Law DH, McCleery JL. Azathioprine-related pancreatitis in patients with Crohn's disease. Gastroenterology 1979; 77:883-6. [PMID 38178]
23. Villarreal HA, Wells LD, Neusschwander-Tetri BA. Azathioprine induced acute pancreatitis in mice. Gastroenterology 1995; 108(Suppl.):A398. ]
24. Foitzik T, Forgacs B, Ryschich E, Hotz H, Gebhardt MM, Buhr HJ, Klar E. Effect of different immunosuppressive agents on acute pancreatitis. A comparative study in an improved animal model. Transplantation 1998; 65:1030-6. [PMID 9583861]
25. Kamisawa T, Yoshiike M, Egawa N, Nakajima H, Tsuruta K, Okamoto A. Treating patients with autoimmune pancreatitis: results from a long-term follow-up study. Pancreatology 2005; 5:234-8. [PMID 15855821]
26. Okazaki K, Uchida K, Chiba T. Recent concept of autoimmune-related pancreatitis. J Gastroenterol 2001; 36:293-302. [PMID 11388391]
27. Kubota K, Iida H, Fujisawa T, Yoneda M, Inamori M, Abe Y, et al. Clinical factors predictive of spontaneous remission or relapse in cases of autoimmune pancreatitis. Gastrointest Endosc 2007; 66:1142-51. [PMID 18061714]
28. Wakabayashi T, Kawaura Y, Satomura Y, Watanabe H, Motoo Y, Sawabu N. Long-term prognosis of duct-narrowing chronic pancreatitis: strategy for steroid treatment. Pancreas 2005; 30:31-9. [PMID 15632697]
29. Matsushita M, Yamashina M, Ikeura T, Shimatani M, Uchida K, Takaoka M, Okazaki K. Effective steroid pulse therapy for the biliary stenosis caused by autoimmune pancreatitis. Am J Gastroenterol 2007; 102:220-1. [PMID 17278279]
30. Kamisawa T, Okamoto A. Prognosis of autoimmune pancreatitis. J Gastroenterol 2007; 42(Suppl 18):59-62. [PMID 17520225]
31. Muraki T, Hamano H, Ochi Y, Arakura N, Takayama M, Komatsu K, et al. Corticosteroid-responsive pancreatic cyst found in autoimmune pancreatitis. J Gastroenterol 2005; 40:761-6. [PMID 16082595]
32. Nishimura T, Masaoka T, Suzuki H, Aiura K, Nagata H, Ishii H. Autoimmune pancreatitis with pseudocysts. J Gastroenterol 2004; 39:1005-10. [PMID 15549456]
33. Heneghan MA, McFarlane IG. Current and novel immunosuppressive therapy for autoimmune hepatitis. Hepatology 2002; 35:7-13. [PMID 11786954]
34. Poupon R, Poupon RE. Treatment of primary biliary cirrhosis. Baillieres Best Pract Res Clin Gastroenterol 2000; 14:615-28. [PMID 10976018]
35. Weersma RK, Peters FT, Oostenbrug LE, van den Berg AP, van Haastert M, Ploeg RJ, et al. Increased incidence of azathioprine-induced pancreatitis in Crohn's disease compared with other diseases. Aliment Pharmacol Ther 2004; 15:834:50. [PMID 15479355]
36. Bajaj JS, Saeian K, Varma RR, Franco J, Knox JF, Podoll J, et al. Increased rates of early adverse reaction to azathioprine in patients with Crohn's disease compared to autoimmune hepatitis: a tertiary referral center experience. Am J Gastroenterol 2005; 100:1121-5. [PMID 15842588]
37. Umemura T, Zen Y, Hamano H, Joshita S, Ichijo T, Yoshizawa K, et al. Clinical significance of immunoglobulin G4-associated autoimmune hepatitis. J Gastroenterol 2011; 46(Suppl 1):48-55. [PMID 20862498]